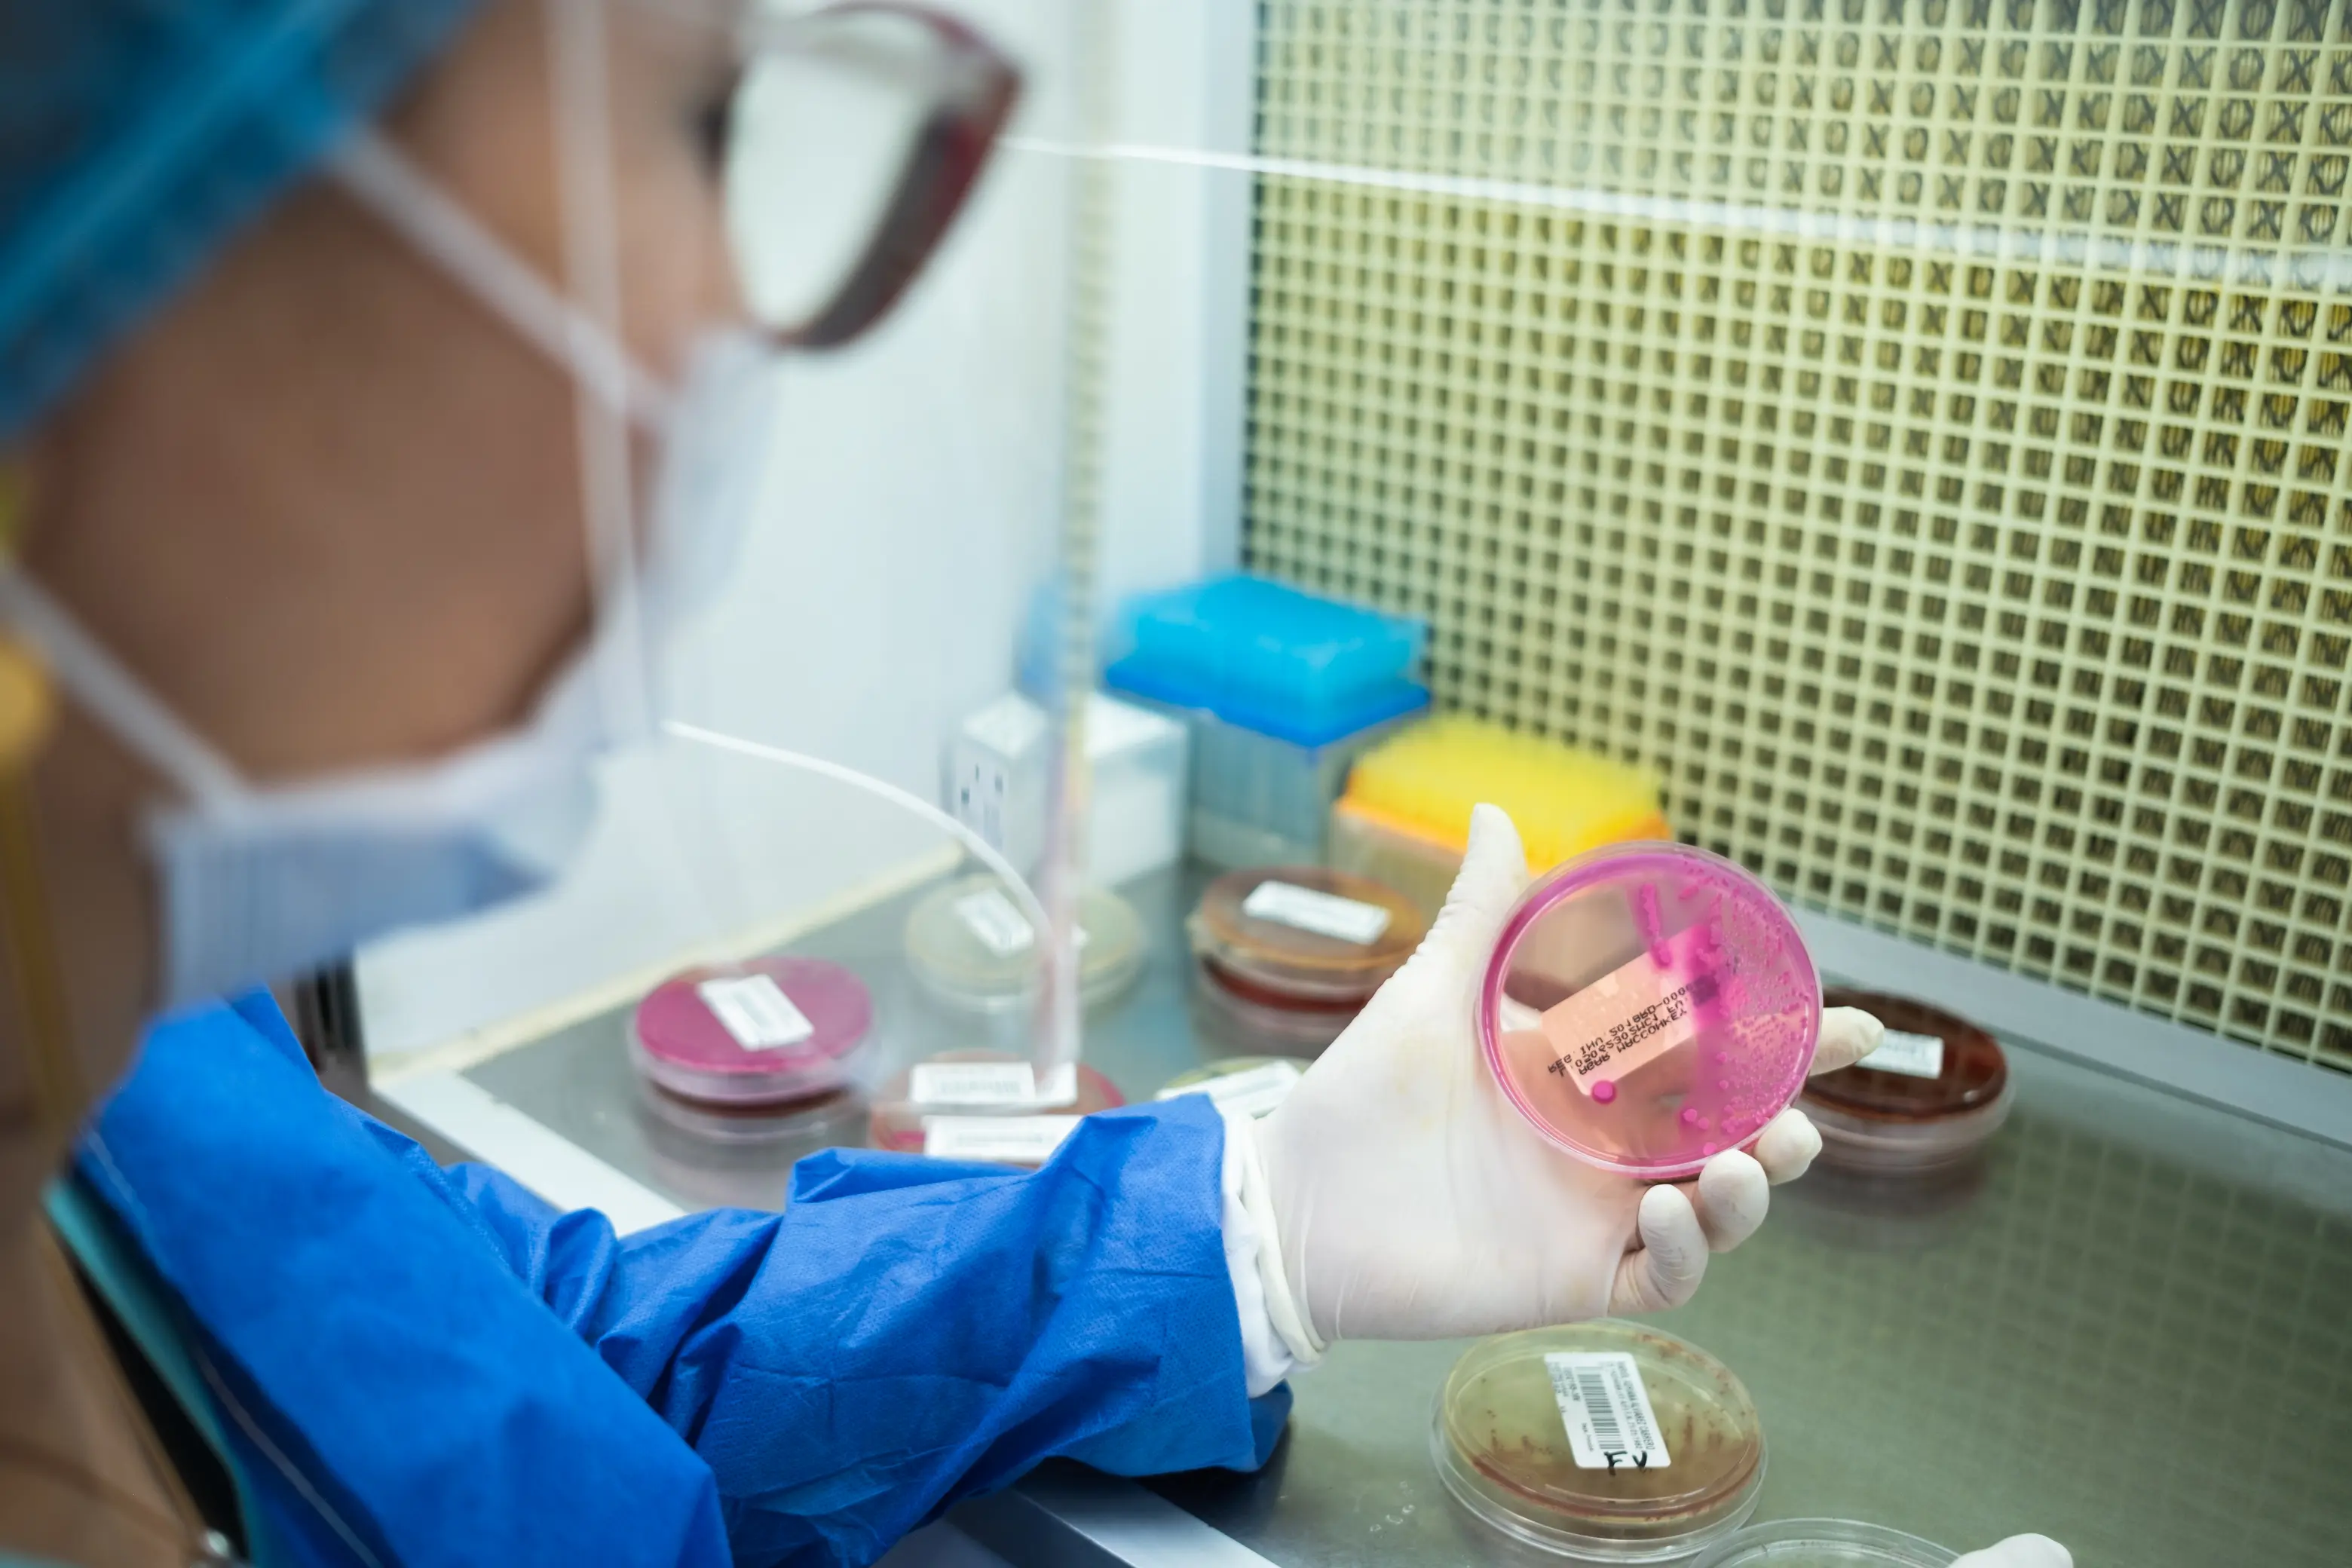
Servicio 13

SERVICIOS
Pruebas clinicas
Biología Molecular
Uroanálisis y coproanálisis
Química clínica
Microbiología
Coagulación
Enfermedades infecciosas
Hormonas
Marcadores tumorales
Hematología
Perfiles diagnósticos

Perfil Estudio metabólico de la litiasis renal
Estudio metabólico de la litiasis renal

Perfil Fertilidad Masculina
Evalúa parámetros clave para determinar la salud reproductiva masculina.

Perfil Nutricional
Diseñado para evaluar el estado metabólico y nutricional de una persona.

Perfiles Prenatales
Una serie de pruebas fundamentales para garantizar el bienestar de la madre y el bebé durante las diferentes etapas del embarazo, identificando riesgos y previniendo complicaciones.

Perfil Infecciones de Transmisión Sexual
Evalúa la presencia de infecciones de transmisión sexual con exámenes clave para un diagnóstico integral.

Perfil Tiroideo
Analiza el funcionamiento de la glándula tiroides y permite diagnosticar posibles enfermedades tiroideas.

Perfil Renal
Detecta posibles alteraciones en la función de los riñones y evalúa su capacidad para filtrar desechos y proteínas.

Perfil Lipídico
Evalúa el estado de las grasas en la sangre para prevenir enfermedades cardiovasculares

Perfil Reumático
Detecta enfermedades autoinmunes y reumáticas que afectan articulaciones, músculos y otros tejidos.

Perfil Marcadores Tumorales
Son un conjunto de pruebas especializadas para detectar la presencia de ciertos tipos de cáncer y monitorear el estado de salud del paciente.

Perfil Hormonal Femenino
Evalúa el equilibrio hormonal femenino, esencial para diagnosticar condiciones ginecológicas y reproductivas.

Perfil Diabético
Monitorea y diagnostica diabetes, además de evaluar el control metabólico del paciente.
Perfil Hepático
Evalúa la salud y función del hígado, detectando posibles anomalías en su actividad.

